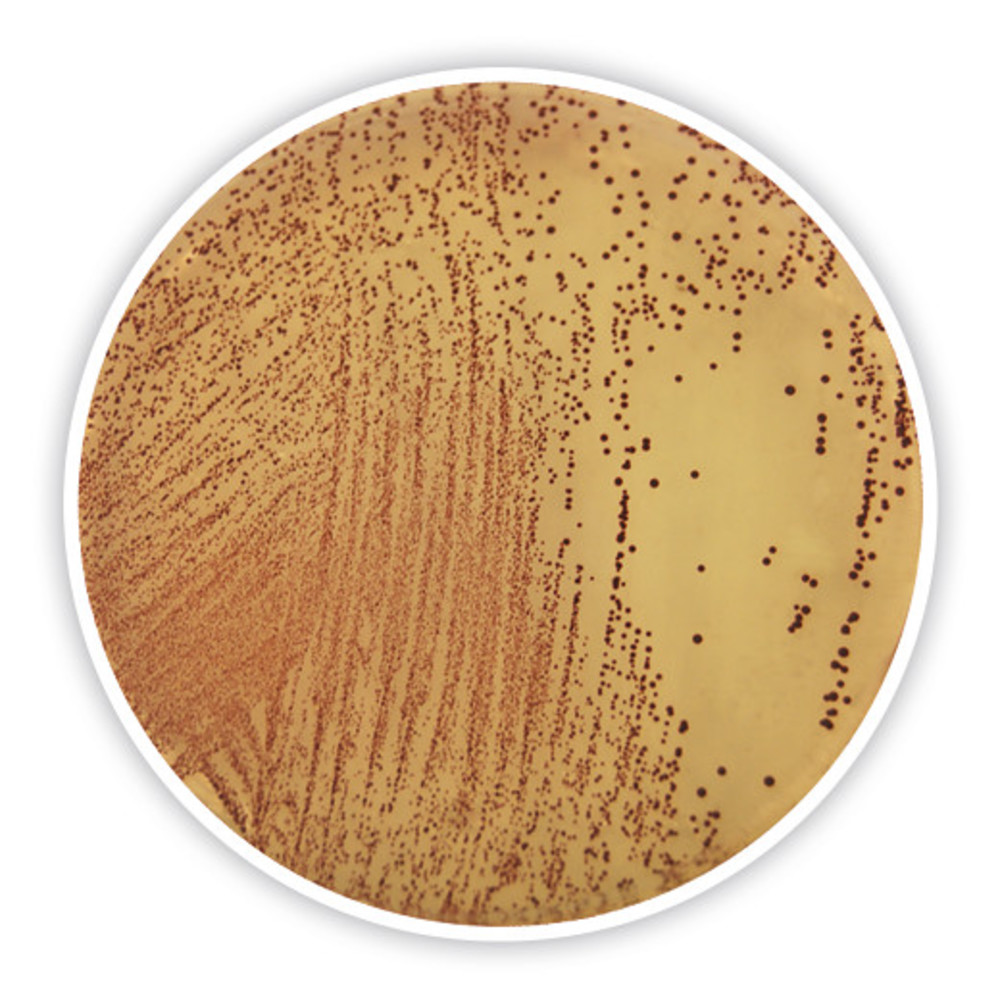
CP68.1, Carl

Products Found:
9
Showing Results For:
Media for Enterobacteria
Media for Enterobacteria
Violet Red Bile Agar with Dextrose and Lactose
MF Part:
AE45.1
MOQ:
1 -
£ 173.21
Get Quote
more details
Slanetz-Bartley Medium (with tetrazolium chloride)
MF Part:
CP68.1
MOQ:
1 -
£ 208.04
In Stock
more details